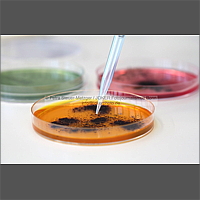

080424 5102 41
|
 080500 5100 01
|
 080500 5101 52
|
080500 5101 61
|
 080500 5101 63
|
 080500 5101 66
|
 080500 5101 69
|
 080500 5101 73
|
 080500 5101 78
|
 080500 5101 80
|
 080500 5101 82
|
 080500 5101 86
|
 080508 5101 03
|
 080508 5101 04
|
 080508 5101 06
|
 080508 5101 09
|
 080508 5101 12
|
 080508 5101 15
|

